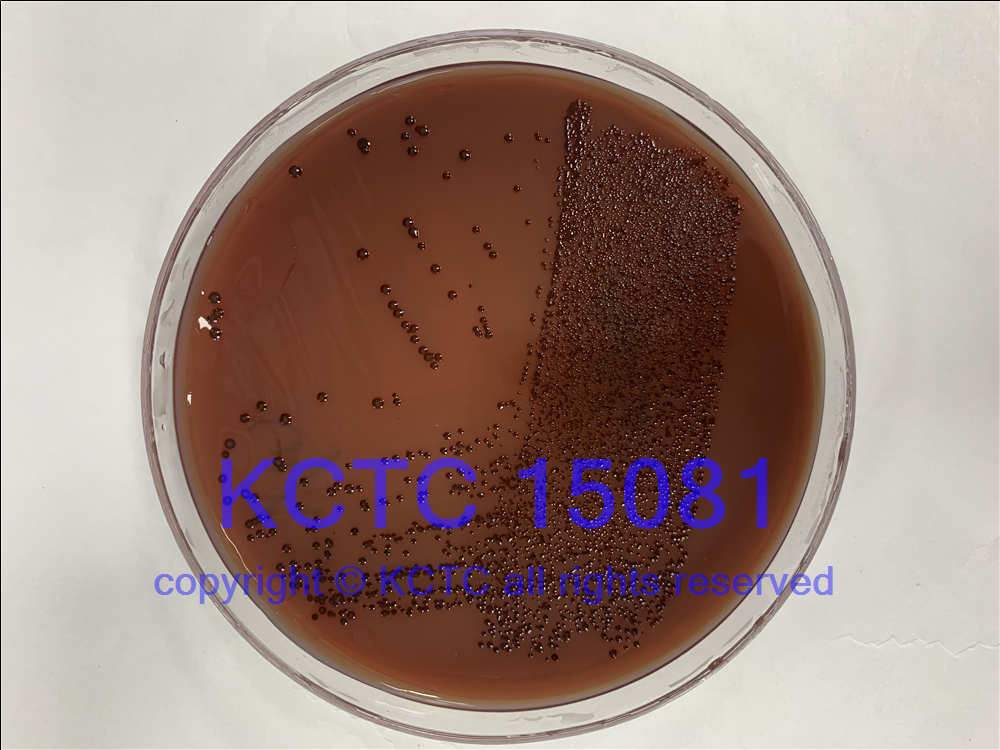

Name:
Prevotella nigrescens Shah and Gharbia 1992 emend. Hahnke et al. 2016
DSM No.:
13386, Type strain
Strain designation:
ATCC 33563, NCTC 9336, Lambe 729-74, VPI 8944
Other collection no.
or WDCM no.:
ATCC 33563,NCTC 9336 KCTC15081
Isolated from:
Vincent's gingivitis
Country:
England
Nagoya Protocol Restrictions:
There are NO known Nagoya Protocol restrictions for this strain.
History:
<- ATCC; ATCC 33563 <- VPI; VPI 8944 (Bacteroides intermedius) <- NCTC; NCTC 9336 <- M. E. Sharpe; <- L.P. Garrod; Lambe 729-74
Genbank accession numbers:
16S rRNA gene: AB547696
whole genome shotgun sequence: AFPX00000000
Cultivation conditions:
Medium 104 + haemine (5µg/ml) + Vit K1, 37°C
or
Medium 78 , 37°C
or
Medium 693 , 37°C
Incubation time: 1-2 days
Please follow special instructions: 'Cultivation of Anaerobes'
Complete DSMZ Media List
Summary and
additional information:
<- ATCC; ATCC 33563 <- VPI; VPI 8944 (Bacteroides intermedius) <- NCTC; NCTC 9336 <- M. E. Sharpe; <- L.P. Garrod; Lambe 729-74. Vincent's gingivitis. England. Sampling Date: before 01.10.1992. Taxonomy/description (7744, 26748, 26962). Sequence accession no. 16S rRNA gene: AB547696, whole genome shotgun sequence: AFPX00000000. (Medium 104 + haemine (5µg/ml) + Vit K1, incubation time: 3-7 days, gas phase: 100%N2, pH 7, 37°C, anaerobic or Medium 78, incubation time: 3-7 days, gas phase: 100%N2, pH 7, 37°C, anaerobic or Medium 693, incubation time: 3-7 days, gas pack, pH 7, 37°C, anaerobic)
Literature:
7744, 26748, 26962
Risk group:
2 (classification according to German TRBA)
Restrictions:
Act dealing with the prevention & control of infectious diseases in man (Infektionsschutzgesetz), Category A1
Supplied as:
Delivery form Prices
Freeze Dried
Active culture on request
DNA
Price Category for this culture: 1
Freight and handling charges will be added. See price list.
Note: Freight charges for Risk Group 2 microorganisms will apply.
DSM13386